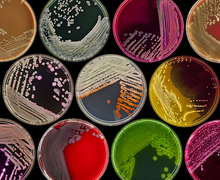

Local organizations ‘Clean up ‘Cuse’ this Earth Day
The litter cleanup event will be held Saturday and Sunday and is organized by the City of Syracuse and Onondaga County Resource Recovery Agency. Read more »

The litter cleanup event will be held Saturday and Sunday and is organized by the City of Syracuse and Onondaga County Resource Recovery Agency. Read more »

Mike Nunes graduated from the S.I. Newhouse School of Public Communications in 2002 and started his career at NBC in 2006, and he has climbed the entertainment ladder ever since. Read more »

Thornden Park Association has been working over the last 35 years to restore the historic park and make it more accessible to the Syracuse community. Read more »

In a time when public funding for the arts is lacking, Syracuse arts organizations just received $300,000 worth of grants. Read more »
Two medical experts collaborate to bridge the gap between photography and science in SUArt Galleries’ newest photo exhibit, on display now until March 9. Read more »

Justyna Badach, artist and refugee, uses her work to explore the futility of conflict and the American media’s glorification of hyper-masculinity. Read more »

As a teenager, she didn’t see herself as beautiful. Now, after a journey of self-love and acceptance, LaNia Roberts aims to inspire others with her art. Read more »

This Friday, Gathering Time will play folk classics and original songs at the May Memorial Unitarian Universalist Society as part of the Folkus Project. Concertgoers can expect harmony, energy, humor and joy during the set. Read more »

The Syracuse organization strives to cultivate a safe environment for LGBT people of color — which its creator said she couldn’t find in the community. Read more »

Burns and Kristy, a husband-and-wife folk music duo, are playing in Syracuse this weekend. They had separate music careers, but during their marriage, they evolved into a band. Read more »

Sebastian Maniscalco always knew he wanted to be a comedian. Now, he's one of the highest paid in his field and is making a stop in Syracuse this week. Read more »

It’s been nearly a year since the Trump administration announced a plan to gut federal funding for the arts. Central New York’s arts organizations are doing their best to stay positive. Read more »

Syracuse Stage and Syracuse University’s Department of Drama have partnered with 2 Ring Circus to present “The Wizard of Oz” with a Cirque du Soleil twist. Read more »

The Gifford Foundation will conclude on Wednesday its film series “What If…” to highlight the negative effects of child abuse. Read more »